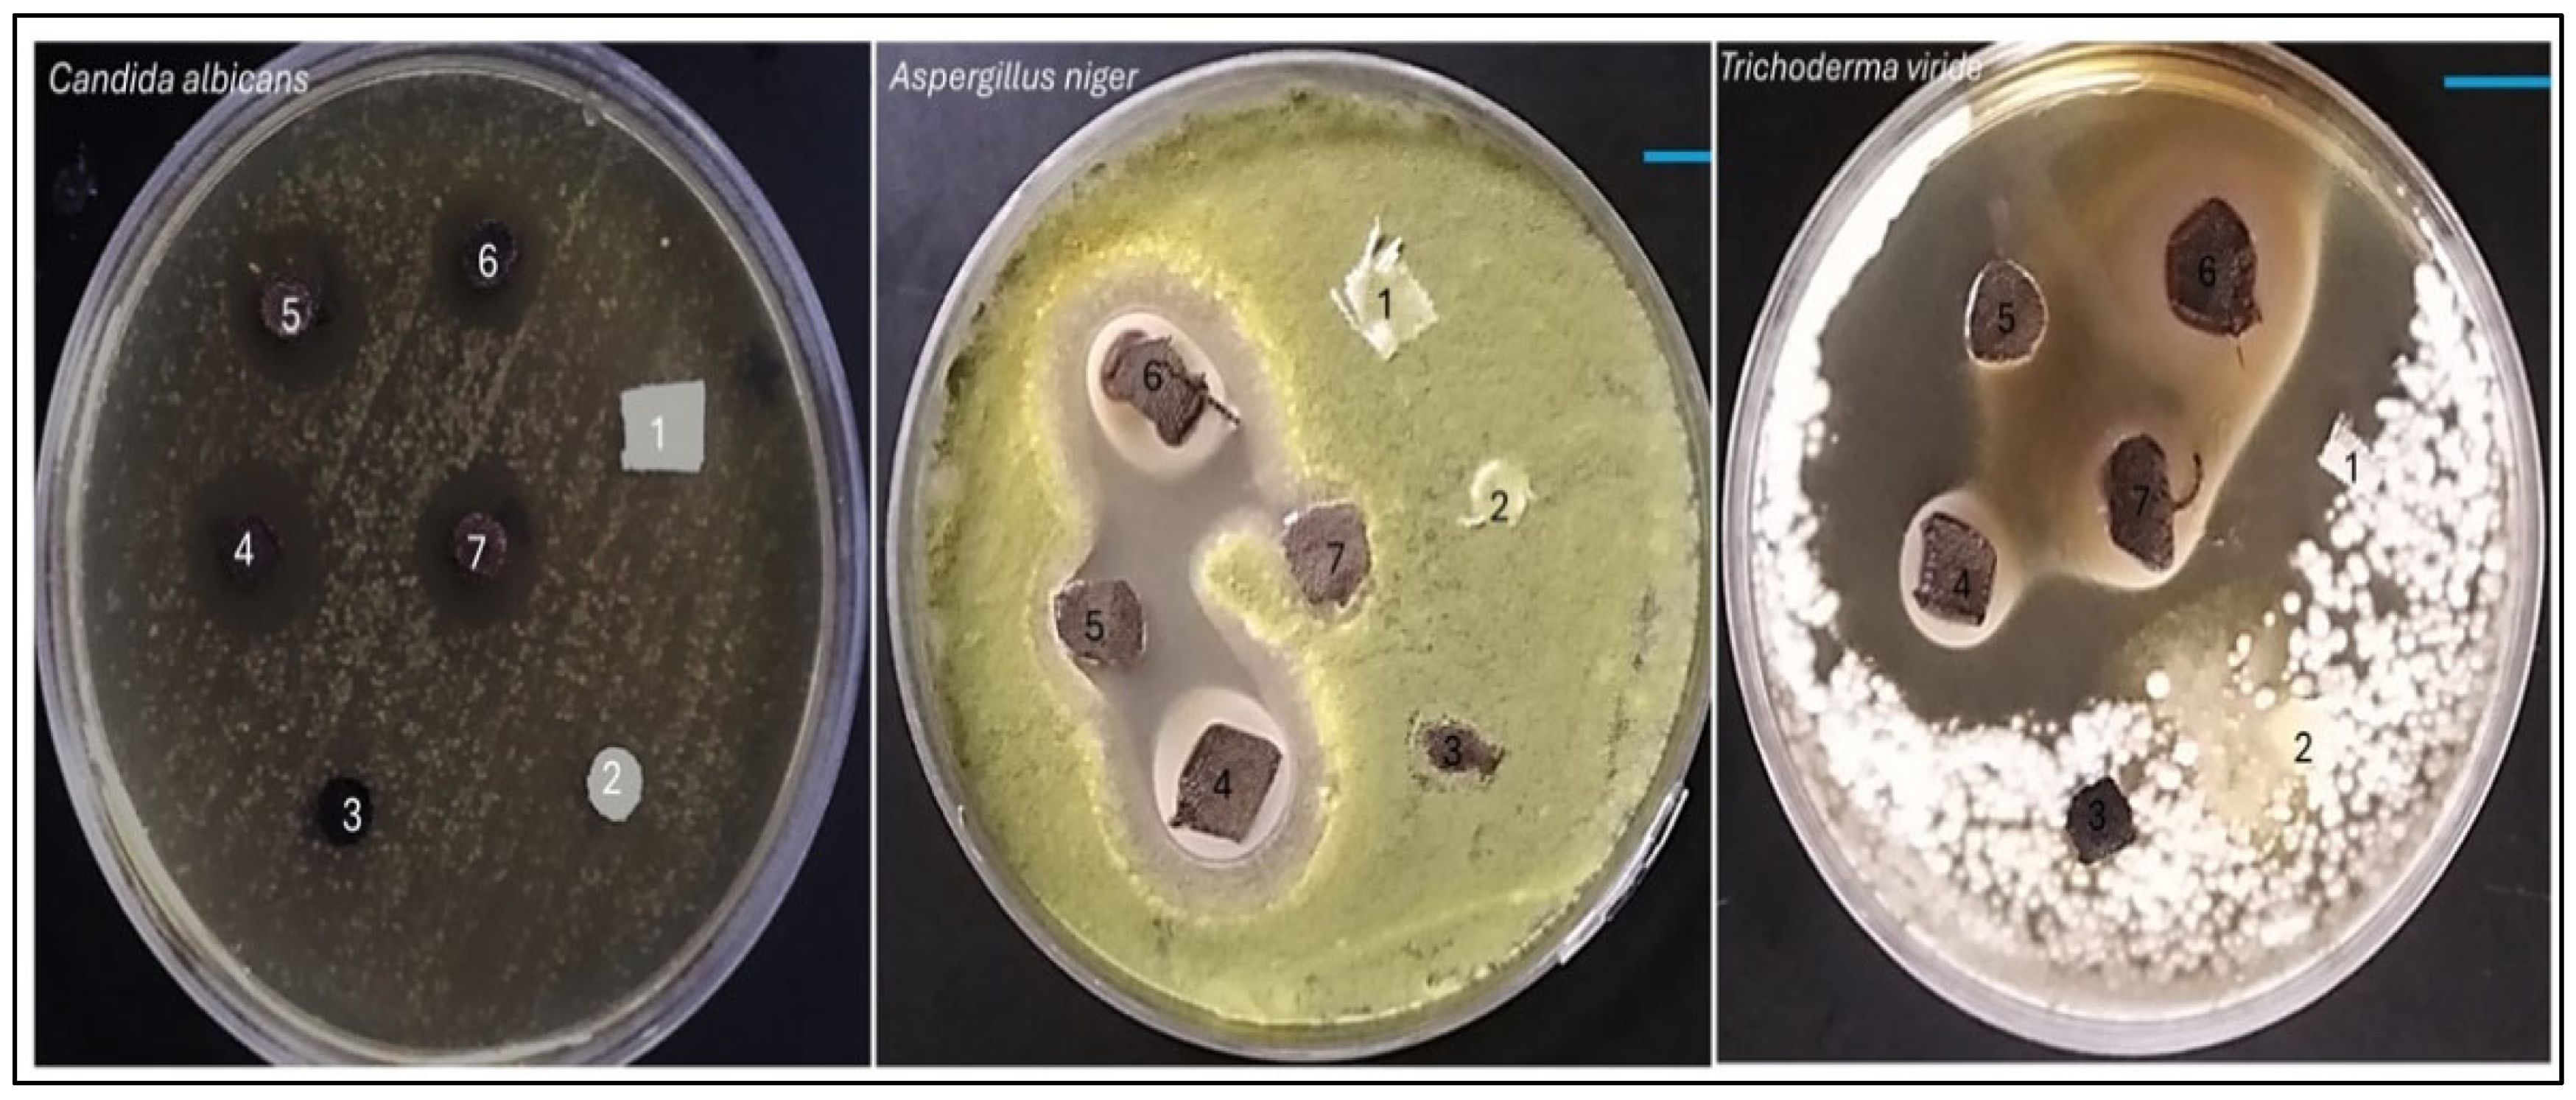
Textiles 06 00016 g010

Abstract
This manuscript reports a green approach for producing multifunctional acrylic fabrics co-decorated with Fe3O4 and Ag nanoparticles using Brachychiton populneus extract. Acrylic fabric was first amidoxime-functionalized to enable strong anchoring of Fe3O4 nanoparticles, followed by in situ deposition of AgNPs, during which the extract’s phytochemicals acted as reducing and stabilizing agents. FTIR, SEM/EDX, and VSM analyses confirmed successful surface modification and nanoparticle incorporation. The sequential treatments produced measurable add-on values (16.7% after amidoximation, followed by 10.9% and 8.5% after Fe3O4 and AgNP deposition, respectively). The Ag/Fe3O4-coated fabrics exhibited enhanced hydrophobicity and strong antimicrobial activity, with inhibition zones up to 14 mm against bacteria (including MRSA) and 26.9 mm against fungi at the highest Ag loading. Antioxidant activity was also markedly improved, showing up to a 78-fold increase in reducing power. Overall, this sustainable plant-mediated route provides an effective strategy for developing antimicrobial and antioxidant acrylic textiles for technical and protective applications.
1. Introduction
Acrylic fibers, or polyacrylonitrile (PAN) fibers, are pivotal in the textile industry due to their soft, wool-like texture, chemical resistance, and strong mechanical properties. By 2023, their global market value reached approximately USD 5.47 billion, up from USD 5.30 billion in 2022, driven by rising demand across sectors such as fashion, home textiles, and various industrial applications. Projections estimate the market will grow to around USD 8.0 billion by 2033, reflecting a compound annual growth rate (CAGR) of about 4.2% [1]. Acrylic textiles offer unique opportunities for durable surface functionalization. The nitrile-rich backbone of acrylic fibers enables facile chemical conversion into amidoxime groups, which provide strong coordination sites for metal and metal-oxide binding. This ligand-assisted anchoring is particularly advantageous for producing stable nanoparticle coatings with minimized leaching, an essential requirement for functional textiles designed for repeated use. Produced primarily by polymerizing acrylonitrile with other vinyl monomers, acrylic fibers include homopolymer PAN and modacrylics, catering to diverse industrial needs such as carbon fiber production and filtration systems [2]. In recent years, improving the functional performance of acrylic fabrics—particularly antimicrobial activity and water resistance—has attracted increasing attention. From an industrial perspective, such functionalities are typically introduced using scalable finishing routes including wet-chemical treatments and coating/impregnation methods (e.g., pad–dry–cure and exhaustion-based finishing), as well as nanoparticle-assisted functional coatings [1,3,4]. These approaches enable durable surface modification while maintaining process feasibility and compatibility with textile manufacturing. For example, integrating silver nanoparticles imparts antimicrobial effects, while titanium dioxide provides UV protection [5,6]. Modified acrylic fabrics with hydrophobic surfaces can be achieved through various methods, such as coating with nanoclay or hydrophobically modifying poly(acrylic acid) (HMPA) films [7,8]. These modifications enhance properties such as moisture regain, UV protection, and air permeability while also improving the fabric’s antimicrobial activity [7]. By creating hydrophobic domains in the fabric, the antimicrobial activity against pathogens such as Staphylococcus aureus and Escherichia coli can be significantly increased, leading to up to 100% growth inhibition in some cases [8]. Additionally, treating the surface of acrylic resin films with specific compounds can provide excellent antifogging and antifouling properties while maintaining high transparency, further enhancing the fabric’s functionality and durability [9]. These findings suggest that modified acrylic fabrics with hydrophobic surfaces can offer a multifunctional solution for various applications requiring antimicrobial properties.
The development of antimicrobial textiles has become a major focus of materials science, driven by increasing demands from the healthcare, sportswear, and protective clothing sectors [10,11]. Current research progress is largely centered on the integration of inorganic nanoparticles, with silver nanoparticles (AgNPs) being particularly favored for their potent, broad-spectrum antimicrobial efficacy [3]. However, the field is rapidly evolving to address key challenges such as the environmental impact of chemical synthesis and the long-term durability of nanoparticle coatings. Consequently, there is a significant trend towards adopting green synthesis methods that utilize plant extracts as non-toxic reducing agents [12]. Furthermore, to enhance stability and prevent the leaching of nanoparticles during use, researchers are increasingly exploring hybrid nanocomposite systems, where antimicrobial agents like silver are combined with anchoring materials to create more robust and effective functional textiles [13,14].
The reactive cyano groups in acrylic fibers can be transformed into specific functional groups to suit multiple applications [15,16]. Converting cyano groups to amidoxime groups with hydroxylamine hydrochloride enhances the fabric’s hydrophilicity and metal-ion binding capacity [16]. A key strategy for achieving durable nanoparticle coating involves the chemical modification of the textile substrate to create strong binding sites. For acrylic fabrics, which are based on polyacrylonitrile, the native cyano groups (-C≡N) offer a unique opportunity for functionalization. Through a well-established reaction with hydroxylamine, these cyano groups can be converted into amidoxime moieties (-C(=NOH)NH2). The amidoxime group is a powerful bidentate chelating ligand, capable of forming strong coordinate bonds with a wide range of metal ions through its nitrogen and oxygen donor atoms [17,18]. This strong chelating ability has been extensively utilized for the extraction of heavy metal ions from aqueous solutions [19]. In the context of functional textiles, this mechanism can be strategically employed to immobilize metal-based nanoparticles, such as magnetite (Fe3O4), onto the fabric surface, creating a stable, anchored platform for further functionalization [20].
Polymers containing amidoxime have demonstrated effective adsorption of heavy metal ions [21,22,23]. Incorporating Fe3O4 nanoparticles as nanofillers in polymeric coatings has been shown to reduce total free volume and increase cross-linking density by acting as molecular bridges [24]. Moreover, Ag–Fe3O4 hybrid nanoparticles exhibit superior antibacterial activity against E. coli compared to standalone Ag nanoparticles. This enhancement is attributed to a higher release rate of Ag+ ions facilitated by electron transfer from Ag to Fe3O4 nanoparticles and accelerated ionization of Ag nanoparticles in the presence of Fe3+ ions [25]. In this work, the focus is the development of multifunctional acrylic-based technical textiles with hygienic functionality, where antimicrobial activity is required to reduce microbial colonization on fabric surfaces and antioxidant activity improves resistance to oxidative degradation. Acrylic fabric was functionalized with amidoxime groups to act as effective ligands for anchoring magnetite (Fe3O4) nanoparticles, followed by the in situ green deposition of silver nanoparticles (AgNPs) using Brachychiton populneus extract as an eco-friendly reducing and stabilizing agent. The polyphenolic/flavonoid constituents of the extract promote the reduction in Ag+ to AgNPs and enable the formation of an Ag/Fe3O4 co-decorated coating directly on the fiber surface, imparting enhanced antimicrobial and antioxidant performance. Moreover, AgNP incorporation contributes to a pronounced increase in surface hydrophobicity, which is attributed to the hierarchical nanoscale texture created on the fabric surface, promoting water-repellent behavior [26]. The novelty of this study lies in the rational and synergistic integration of amidoxime-based chelation anchoring, magnetite immobilization, and plant-mediated AgNP formation into a single sequential strategy, yielding a durable multifunctional coating. The study is therefore primarily positioned toward protective and technical textile applications, while biomedical or hospital-related applications are considered a potential future direction that would require additional biocompatibility and safety evaluations beyond the scope of this work.
2. Materials and Methods
The acrylic textile fabric used in this study was supplied by Misr El-Mahalla Co., El-Mahalla El-Kubra, Egypt. The fabric was woven in a plain weave (1/1) structure with a thread count of 40.6 threads per inch (TPI) in both the warp and weft directions. The fabric density was 0.36 g/cm3. Acrylic fibers are generally polyacrylonitrile (PAN)-based copolymers, containing a high density of nitrile (–C≡N) groups, which provide an effective chemical platform for amidoximation and subsequent nanoparticle immobilization. The necessary substances for the study, such as sodium acetate, hydroxylamine hydrochloride, ferric nitrate hexahydrate, ferric chloride, ferrous sulfate, silver nitrate, 2,4,6-tripyridyl-s-triazine (TPTZ), hydrochloric acid (HCl, 37%), ethanol, and 2,2-Diphenyl-1-picrylhydrazyl (DPPH) were obtained from Sigma-Aldrich (Burlington, MA, USA).
2.1. Amidoximated Acrylic Fabric
A process of preparation involving the amidoximation of acrylic fabric was undertaken. Three grams of the fabric were subjected to treatment utilizing a solution consisting of 2% aqueous sodium acetate and 1% hydroxylamine hydrochloride, with a liquor-to-goods ratio of 50:1. This procedure was executed at a temperature of 85 °C for a duration of two hours. Following the treatment process, the fabric underwent rinsing with distilled water and acetone and was subsequently allowed to dry naturally. The resulting modified acrylic fabrics are commonly denoted as treated acrylic fabric (TAC).
2.2. Brachychiton populneus Extract
Brachychiton populneus leaves were collected from Qalyubia Governorate, North Cairo, Egypt (30°14′28″ N, 31°19′59″ E). The collected leaves were washed thoroughly with tap water followed by distilled water to remove dust and surface impurities and then air-dried and stored prior to extract preparation. The Brachychiton populneus leaves were ground into a fine powder. Subsequently, 10 g of the powdered B. populneus was mixed with 100 mL of ethanol and left on a shaker overnight. The mixture was then filtered, and the resulting filtrate was collected for further use.
2.3. Silver-Magnetite Co-Decorated Amidoximated Fabric
In 50 mL of distilled water, 0.8 g of ferric chloride (FeCl3) was dissolved and mixed with 0.4 g of ferrous sulfate (FeSO4). Then, 2 g of amidoximated acrylic fabric (TAC) was immersed in the Fe3+/Fe2+ precursor solution and soaked overnight to allow sufficient uptake of iron ions by the amidoxime-functionalized surface. After soaking, the fabric was transferred to a 1 M NaOH solution and treated at 70 °C for 5 min to induce in situ precipitation of magnetite (Fe3O4) onto the textile surface. The resulting black fabric was thoroughly washed with distilled water to remove residual alkali and unbound salts and then dried at 60 °C to obtain Fe3O4-coated treated acrylic fabric (Fe3O4-TAC). For AgNP deposition, Fe3O4-TAC was immersed in Brachychiton populneus extract using a liquor-to-goods ratio (L:G) of 30:1. The mixture was heated at 70 °C for 1 h to promote adsorption of phytochemicals onto the fabric/nanoparticle surface and then left to soak overnight. Subsequently, aqueous AgNO3 solution was added directly into the same bath (final AgNO3 amounts: 0.1, 0.2, 0.4, and 0.8 mmol), and the reaction mixture was allowed to stand overnight to enable plant-mediated reduction in Ag+ into AgNPs and their deposition on the fabric. AgNO3 was introduced as an aqueous solution to avoid precipitation and to ensure homogeneous availability of Ag+ ions in the reaction bath. After completion, the treated fabrics were rinsed thoroughly with distilled water and dried at 60 °C. It should be noted that, under these synthesis conditions, AgNPs formed in situ may deposit onto the immobilized Fe3O4 nanoparticles and/or directly onto the amidoxime-functionalized acrylic surface; thus, the coating is best described as an Ag/Fe3O4 co-decorated textile.
2.4. Characterization of Modified Acrylic Fabric
The magnetic properties of Fe3O4-TAC and Ag/Fe3O4-TAC were assessed utilizing a vibrating sample magnetometer (VSM, Model 7400, Lake Shore Cryotronics, Inc., Westerville, OH, USA). Fourier-transform infrared spectroscopy (FTIR) was employed, through a PerkinElmer Spectrum 100 device, to analyze the chemical composition of pristine acrylic (AC), TAC, Fe3O4-TAC, and Ag/Fe3O4-TAC.
The investigation into the surface morphology of AC, TAC, Fe3O4-TAC, and Ag/Fe3O4-TAC was conducted using field-emission scanning electron microscopy (FESEM, JSM-7800F) coupled with a Bruker Nano (Berlin, Germany), an XFlash 5010 detector, and energy-dispersive X-ray spectroscopy (EDX). The determination of the specific surface area of AC, TAC, Fe3O4-TAC, and Ag/Fe3O4-TAC was achieved successfully through the Brunauer-Emmet-Teller (BET) method. N2 adsorption–desorption analysis at 77 K was performed using a Quantachrome Touchwin v1.21 devices (DataPhysics Instruments GmbH, Filderstadt, Germany). The evaluation of the pore size distribution was obtained by analyzing the adsorption branch with the BJH (Barett-Joyner-Halenda) method. The pore volume was determined utilizing the Quantachrome ASiQwin device in conjunction with the Density Functional Theory (DFT) approach. Surface wettability changes in the treated acrylic fabrics were evaluated by water contact angle measurements using a fully computer-controlled OCA20 contact angle analyzer (DataPhysics, Filderstadt, Germany). The measurements were conducted at room temperature using the sessile drop technique. A distilled water droplet (5 μL) was carefully deposited onto the fabric surface using a microsyringe, and the contact angle was recorded 10 s after droplet placement to allow stabilization while minimizing evaporation and absorption effects. For each sample, measurements were repeated at a minimum of five different locations, and the results are reported as the mean ± standard deviation. Tensile strength and elongation at break were measured using a Universal Testing Machine Galdabini Quasar 50 kN (Spectrographic Ltd., Leeds, UK) with a cross-head speed of 300 mm/min and 25 kN load cell. The tensile strength was determined following ISO 2307:2010 [27].
2.5. Antimicrobial Activity
2.5.1. Antibacterial Activity
Three bacterial strains, specifically American type culture collection (ATCC)-characterized Pseudomonas aeruginosa (PA) (ATCC 27853), Salmonella Typhimurium (ST) (ATCC 14028), and methicillin-resistant S. aureus (MRSA ATCC 43300), were inoculated at a concentration of 106 CFU/mL onto Mueller Hinton Agar Media (MHA). The selected bacterial strains represent both Gram-positive and Gram-negative clinically relevant pathogens, including resistant strains (MRSA), to evaluate broad-spectrum antimicrobial performance under challenging conditions. Disks comprising AC, TAC, Fe3O4-TAC, along with silver nanoparticles incorporated on magnetite Fe3O4-TAC at concentrations of 1, 2, 3, and 4 mmol (Ag/Fe3O4-TAC), were fabricated and subsequently positioned on the MHA plates. Following a 30 min diffusion interval at refrigeration temperatures, the plates were incubated at a controlled temperature of 37 °C for a duration of 24 h. The zones of inhibition were quantified through triplicate experimental trials, employing mean and standard deviation (SD) values for statistical analysis.
2.5.2. Antifungal Activity
The antifungal efficacy of modified acrylic materials was systematically evaluated against Aspergillus niger, Trichoderma viride, and Candida albicans utilizing the disk diffusion technique. Fungal spores were cultivated in Czapek-Dox broth for a period of 48 h. Subsequently, the fungal inoculum was uniformly disseminated on potato dextrose agar (PDA) plates utilizing sterile cotton swabs. Disks composed of AC, TAC, Fe3O4@TAC, and 1, 2, 3, and 4 mmol Ag/Fe3O4-TAC were meticulously prepared and affixed onto the PDA plates. Following a 30 min diffusion period in refrigerated conditions, the plates were then incubated at a temperature of 28 ± 2 °C for a duration of 48 h. The zones of inhibition were evaluated through triplicate trials, with mean and standard deviation (SD) values employed for comprehensive analysis.
2.6. Antioxidant Activity
2.6.1. DPPH Assay
In order to assess the antioxidant capacity of the textile specimens, 30 mg of each sample was immersed in 10 mL of a 0.1 mM DPPH methanol solution and subsequently incubated for varying durations (1, 2, and 4 h) at a temperature of 37 °C within an incubator maintained in a dark environment. The absorbance of the solutions at predetermined time intervals was recorded at a wavelength of 515 nm utilizing a UV-Visible spectrophotometer. The antioxidant efficacy was quantified by employing the following equation [28].
where A0 represents the absorbance of DPPH solutions devoid of fabric sample, and Af denotes the absorbance of DPPH solutions containing the fabric sample at 515 nm.
Antioxidant efficiency (%) = [(A0 − Af)/A0] × 100
2.6.2. Ferric Reducing Antioxidant Power Assay (FRAP)
The methodology articulated by Benzie and Strain (1996) was implemented with minor modifications [29]. The fundamental principle of this approach is predicated upon the reduction in a ferric 2,4,6-tripyridyl-s-triazine complex (Fe3+–TPTZ) to its ferrous, chromatically active form (Fe2+–TPTZ) in the presence of antioxidant agents. The FRAP reagent was composed of 2.5 mL of a 10 mM TPTZ (2,4,6-tripyridyl-s-triazine) solution in 40 mM HCl, 2.5 mL of 5 mM FeCl3, and 25 mL of a 0.3 M sodium acetate buffer at pH 3.6. This reagent was freshly prepared on a daily basis and subsequently warmed to 37 °C. Aliquots of 30 mg of the sample were combined with 1.8 mL of the FRAP reagent, and the absorbance of the resulting reaction mixture was spectrophotometrically measured at 593 nm following an incubation period of 30 min at 37 °C, using the sugar analog as a reference.
3. Results and Discussion
It was envisaged that the activation of acrylic fabric through the use of hydroxylamine hydrochloride would introduce active amidoxime sites suitable for the attachment of magnetite Fe3O4 NPs, followed by the in situ deposition of silver nanoparticles (AgNPs) onto the Fe3O4-coated acrylic fabric using Brachychiton populneus extract as an environmentally friendly bioactive agent. In accordance with our established methodology, the fabric underwent amidoximation via the reductive transformation of nitrile groups into amidoxime groups, resulting in a weight increase of 16.7%, indicating the successful reduction in nitrile. Subsequently, magnetite Fe3O4 NPs were loaded from an aqueous solution, leading to an absorption of Fe3O4 MNPs as evidenced by a 10.9% weight gain following an overnight immersion in Fe3+/Fe2+ at room temperature. Silver nanoparticles were successfully loaded onto Fe3O4 nanoparticle-integrated acrylic textiles by first immersing the textiles in an ethanolic solution of Brachychiton populneus extract, followed by the gradual addition of silver nitrate. This process resulted in an 8.5% weight gain, indicating effective uptake of AgNPs after overnight exposure. As illustrated in Scheme 1, amidoximation converts nitrile groups (–C≡N) in acrylic (PAN-based) fibers into amidoxime functionalities (–C(=NOH)NH2), which act as ligand sites providing strong coordination/chelation toward Fe3+/Fe2+ species and thereby promote stable immobilization of Fe3O4 nanoparticles. The formation of Fe3O4-coated amidoximated acrylic (Fe3O4–TAC) and the subsequent deposition of AgNPs (Ag/Fe3O4–TAC) are further reflected by the progressive color changes in the textile substrate: the pristine acrylic fabric turns yellowish after amidoximation, then becomes deep black after Fe3O4 coating, confirming effective magnetite deposition, and finally retains a dark appearance with a slightly altered hue after silver loading, suggesting successful incorporation of AgNPs on the Fe3O4-coated surface (Figure 1). In the final step, B. populneus extract mediates the in situ reduction in Ag+ to AgNPs and their deposition onto the Fe3O4-functionalized fabric, yielding an Ag/Fe3O4 co-decorated multifunctional textile. Although the coating showed stable attachment after processing and rinsing steps (supported by SEM/EDX and VSM), further validation through standardized laundering durability (≥10 washing cycles) and abrasion resistance tests is required to confirm long-term performance under repeated-use conditions.
Scheme 1.
Schematic illustration of the stepwise fabrication of Ag/Fe3O4 co-decorated amidoximated acrylic fabric using B. populneus extract.
Figure 1.
Visual appearance of different acrylic fabric modifications (a) Pristine Acrylic (AC), (b) amidoximated acrylic (TAC), (c) magnetite Fe3O4-coated amidoximated acrylic (Fe3O4-TAC), (d) silver nanoparticles loaded on magnetite Fe3O4-coated amidoximated acrylic (Ag/Fe3O4-TAC).
Upon examining the UV-Vis absorption spectra, the ethanolic extract before and after heating at 70 °C display nearly identical absorbance patterns (Figure 2). There is a strong absorbance peak around 200–250 nm in both cases, consistent with the presence of polyphenolic compounds and other organic molecules in the extract. The similarity in these spectra suggests that heating the extract to 70 °C did not significantly alter the composition of the phytochemicals present, indicating that the compounds within the extract are relatively stable under these heating conditions. Following the addition of silver nitrate to the heated extract, a notable change is observed in the UV-Vis spectrum. A distinct absorbance band appears around 420–430 nm, which is characteristic of the surface plasmon resonance (SPR) of silver nanoparticles [30]. This new band confirms the successful formation of silver nanoparticles, likely facilitated by the phytochemicals in the ethanolic extract that act as reducing and stabilizing agents during the nanoparticle synthesis process. The decrease in absorbance around 420–430 nm after AgNO3 addition is attributed to the consumption and oxidation of polyphenolic/flavonoid constituents of the extract during Ag+ reduction. These compounds act as electron donors and are transformed into quinone-like products, causing reduced intensity in the 350–450 nm region. Moreover, since AgNPs are formed mainly by in situ deposition onto the Fe3O4-coated textile, the SPR feature of AgNPs in solution may be weak or masked by the strong extract background.
Figure 2.
UV-Visible absorption spectra of ethanolic extract under different conditions. Comparison of the UV-Visible absorption spectra of the ethanolic extract, ethanolic extract after heating at 70 °C, and ethanolic extract after the addition of AgNO3.
The ATR-FTIR spectra presented in Figure 3 illustrate the chemical transformations occurring in the acrylic fabric at various stages of modification, from pristine acrylic fabric (AC) to amidoximated acrylic (TAC), magnetite Fe3O4-coated amidoximated acrylic (Fe3O4-TAC), and silver nanoparticles loaded on magnetite Fe3O4-coated amidoximated acrylic (Ag@ Fe3O4-TAC). In the pristine acrylic (AC), the broad peak at 3411 cm−1 corresponds to O-H stretching, while the band at 2933 cm−1 is attributed to C-H stretching vibrations from aliphatic groups. The sharp peak at 2246 cm−1 represents nitrile (C≡N) stretching, confirming the presence of polyacrylonitrile (PAN). Additionally, the 1730 cm−1 peak corresponds to carbonyl (C=O) stretching from the vinyl acetate component, indicating the copolymer nature of the fabric. Upon amidoximation (TAC), significant changes are observed. The nitrile peak at 2246 cm−1 diminishes, indicating conversion to amidoxime groups, while a new band at 1638 cm−1 corresponding to C=N stretching confirms the formation of these groups. As previously observed [5], treating fabric with hydroxylamine hydrochloride results in a partial decrease in nitrile groups. The broad peak at 3357 cm−1, representing O-H and N-H stretching vibrations, indicates the presence of hydroxyl and amine functionalities. Additional peaks at 2917 cm−1 and 2848 cm−1 suggest modifications in the fabric’s chemical structure due to amidoximation. After coating the fabric with Fe3O4 nanoparticles (Fe3O4-TAC), further spectral changes are noted. The O-H and N-H stretching vibrations shift to 3193 cm−1, likely due to interactions between amidoxime groups and Fe3O4 nanoparticles. The C=N stretch appears at 1546 cm−1, suggesting complexation between amidoxime groups and the nanoparticles, while new peaks at 1033 cm−1 and 915 cm−1 correspond to Fe-O vibrations. The characteristic Fe3O4 peak at 560 cm−1 confirms successful magnetite deposition [31,32]. Finally, with the addition of silver nanoparticles (Ag/Fe3O4-TAC), the broad O-H/N-H stretching band remains at 3410 cm−1, indicating the persistence of hydroxyl and amine groups. The C=N stretching frequency shifts slightly to 1649 cm−1, suggesting interactions among amidoxime groups, silver nanoparticles, and Fe3O4. The presence of a new peak at 1291 cm−1 may indicate changes in C-N stretching or bending vibrations due to silver incorporation, while the retained Fe-O vibration at 561 cm−1 confirms the continued presence of magnetite nanoparticles.
Figure 3.
FTIR Spectra of different modified acrylic fabrics.
The scanning electron microscopy (SEM) images meticulously documented the alterations in surface morphology of the acrylic fabric throughout various phases of chemical modification. Figure 4a illustrates the acrylic fabric (AC), wherein the surface presents a polished appearance accompanied by a relatively consistent texture. In Figure 4b, the fabric has been subjected to amidoximation (TAC), resulting in an increased roughness of the texture, which serves as an indication of the successful chemical modification of the acrylic surface. Figure 4c portrays the fabric subsequent to the application of magnetite (Fe3O4), wherein the surface exhibits pronounced roughness and irregularities, thereby signifying the effective deposition of Fe3O4 particles onto the amidoximated acrylic (Fe3O4-TAC). Lastly, Figure 4d illustrates the fabric post the integration of silver nanoparticles onto the magnetite-coated surface (Ag/Fe3O4-TAC). The surface displays distinct, luminous spots that correspond to the silver nanoparticles, thereby further substantiating their successful incorporation into the structural matrix of the fabric. High-magnification SEM imaging (Figure 4d) shows that the deposited nanoparticles possess quasi-spherical to irregular morphologies with heterogeneous size distribution. The particles exhibit an estimated apparent diameter of approximately 50–300 nm and are non-uniformly distributed on the fiber surface, with occasional small agglomerates likely formed during localized in situ nucleation and growth. The Energy Dispersive X-ray (EDX) analysis substantiates the effective deposition of Ag@Fe3O4 nanoparticles on the amidoximated acrylic textile (Figure 5). The EDX spectrum, along with the accompanying inset table, reveals that the treated acrylic fabric contains 53.03% and 17.07% by weight of silver and iron, respectively, thereby indicating a successful coating of AgNPs and Fe3O4. EDX, a method recognized for its capability to ascertain bulk chemical compositions through X-ray interactions occurring within a surface depth of approximately 2 μm [33], confirms the existence of essential elements, including silver, iron, oxygen, and carbon.
Figure 4.
SEM at high and low modifications images of acrylic fabrics: (a): AC, (b): TAC, (c): Fe3O4-TAC, and (d): Ag/Fe3O4-TAC.
Figure 5.
EDX spectrum and elemental composition of Ag@Fe3O4-Coated amidoximated acrylic fabric.
After anchoring Fe3O4 nanoparticles on the amidoxime-functionalized acrylic surface, AgNPs were subsequently generated in situ using B. populneus extract. The deposition of AgNPs is subsequently achieved via a plant-mediated green reduction route using B. populneus extract. The polyphenolic/flavonoid constituents (rich in –OH and C=O groups) complex Ag+ ions and promote electron transfer, where phenolic moieties are oxidized to quinone-like structures while Ag+ is reduced to Ag0 nuclei. These nuclei grow into AgNPs directly on the Fe3O4-TAC surface. Moreover, the phytochemicals adsorb on the AgNP surface as capping agents, suppressing aggregation and enhancing particle dispersion, thereby ensuring stable fixation of AgNPs onto the textile substrate.
The magnetic characteristics of Fe3O4-TAC and Ag/Fe3O4-TAC were evaluated (Figure 6). The magnetic hysteresis curves elucidate the correlation between the applied magnetic field (Gauss) and the magnetic moment per unit mass (emu/g) for each material. For the Fe3O4-TAC, the coercivity is quantified at 30 G, accompanied by a magnetization of 0.0334 emu/g. The hysteresis loop for this material exhibits a relatively narrow profile, signifying that it possesses a moderate resistance to fluctuations in its magnetic state and a modest magnetic moment. Such behavior is characteristic of magnetically soft materials, wherein the magnetization can be readily reversed with minimal energy expenditure [34]. Ag/Fe3O4-TAC reveals a reduced coercivity of 18.79 G coupled with a considerably elevated magnetization of 0.1099 emu/g. The hysteresis loop for this material is broader and exhibits a steeper gradient, particularly at the initial slope, which signifies a more robust and rapid magnetic response to the applied field. The diminished coercivity implies that the incorporation of silver nanoparticles decreases the energy requisite for altering the magnetization state, rendering the material more reactive to external magnetic fields [35]. Concurrently, the augmented magnetization reflects an enhanced magnetic moment, likely attributable to the supplementary magnetic contribution from the silver nanoparticles and their interaction with the magnetite coating. The morphology and attributes of the hysteresis loops illustrate that Ag/Fe3O4-TAC demonstrates superior magnetic properties, thereby rendering it more advantageous for applications necessitating high magnetic sensitivity and efficiency. The elevated magnetization and reduced coercivity of Ag/Fe3O4-TAC indicate its capability to achieve a more potent magnetic response with diminished resistance to demagnetization.
Figure 6.
Magnetic hysteresis loops of Fe3O4-TAC and Ag/Fe3O4-TAC.
The adsorption and desorption isotherms presented in Figure 7a illustrate the behavior of various modified acrylic fabrics: AC, TAC, Fe3O4-TAC, and Ag/Fe3O4-TAC. The AC shows a moderate adsorption capacity, with a relatively linear increase in adsorption volume as the relative pressure increases, indicating a homogeneous surface with limited porosity. TAC exhibits slightly higher adsorption and desorption volumes compared to AC, suggesting that amidoximation has introduced more surface functional groups or slight porosity, enhancing the fabric’s adsorption capability. Tsau et al. highlights that the adsorption isotherms demonstrate a linear trend, reinforcing the notion of uniform surface characteristics and minimal pore structure in the materials studied [36]. Similarly, Marco-Lozar et al. report comparable results, noting that the adsorption behavior aligns with models indicative of low porosity and a consistent surface area, further supporting the conclusion of a homogeneous adsorption environment [37]. Fe3O4-TAC demonstrates a further increase in adsorption capacity, which can be attributed to the presence of Fe3O4 nanoparticles that likely increase the surface area and provide additional active sites for adsorption. The desorption curve for this material closely follows the adsorption curve, indicating good reversibility and low hysteresis, suggesting that the adsorption process is primarily physical. Research by Söllner et al. highlights that materials exhibiting such behavior typically have strong interactions that allow for easy desorption, reinforcing the notion of physical adsorption rather than chemical bonding [38]. The most notable behavior is observed in Ag/Fe3O4-TAC, which shows a significantly higher adsorption volume at higher relative pressures (P/P0 > 0.8). This sharp increase suggests that the addition of silver nanoparticles substantially enhances the porosity or surface activity of the fabric, leading to a much higher adsorption capacity. This behavior highlights the potential of Ag/Fe3O4-TAC for applications where high adsorption capacity is essential. The pore structure analysis of the various acrylic fabric samples reveals significant changes in porosity and surface characteristics as the materials undergo chemical modifications (Figure 7b). The AC exhibits the highest BET surface area of 409 m2/g and a total pore volume of 0.302 cm3/g, with a pore diameter of 1.917 nm, indicating a highly porous structure with uniform, small pores (Table 1). Upon amidoximation (TAC), both the surface area and pore volume decrease to 204 m2/g and 0.159 cm3/g, respectively, suggesting that the introduction of functional groups partially blocks the pores and reduces overall porosity. The addition of Fe3O4 nanoparticles (Fe3O4-TAC) increases the surface area to 342 m2/g and the pore volume to 0.262 cm3/g, indicating that the coating process reintroduces some porosity, likely through the formation of nanoparticles that create additional surface area. However, the subsequent incorporation of silver nanoparticles (Ag/Fe3O4-TAC) leads to a significant reduction in both surface area (75.54 m2/g) and pore volume (0.111 cm3/g), with a slightly increased pore diameter of 1.928 nm. This reduction suggests that the silver nanoparticles block smaller pores, resulting in a more compact structure with fewer accessible adsorption sites.
Figure 7.
(a) Nitrogen adsorption–desorption isotherms and (b) pore size distribution of modified acrylic fabrics.
Table 1.
Physicochemical properties of the modified acrylic fabrics.
The contact angle analysis of the acrylic fabric samples reveals significant modifications in their surface properties due to various treatments (Table 2). The pristine acrylic fabric, with a contact angle of 0.0 degrees, demonstrates extreme hydrophilicity, which is characteristic of untreated acrylics known for their water-absorbing capabilities. This hydrophilic behavior persists in the amidoximated acrylic fabric, which also exhibits a contact angle of 0.0 degrees despite the chemical introduction of amine groups. The coating of Fe3O4 nanoparticles on the amidoximated fabric does not alter its hydrophilicity, possibly due to insufficient nanoparticle coverage or the intrinsic properties of Fe3O4, which might not substantially affect the surface energy to influence hydrophilicity. A notable transformation occurs with the amidoximated acrylic fabric coated with Ag/Fe3O4 nanoparticles, where a contact angle of 113.9° indicates a significant shift to hydrophobicity. This change suggests that the silver nanoparticles, in synergy with Fe3O4, profoundly modify the surface characteristics, enhancing the hydrophobic properties. The increase in hydrophobicity is likely due to the unique ability of silver nanoparticles to alter surface energy, influenced by factors such as their treatment, size, distribution, and deposition method on the fabric. This newly introduced hydrophobic property could be particularly advantageous for applications requiring water repellency, such as protective clothing, filtration systems, or other technical textiles designed to offer moisture barrier properties. The observed shift in surface wettability from hydrophilic behavior (AC, TAC, and Fe3O4-TAC) to hydrophobicity after AgNP deposition is attributed to the combined influence of surface morphology and surface chemistry. SEM observations indicate that the in situ formed AgNPs generate a dense nanoscale texture and increase the roughness of the surface, creating a hierarchical micro/nano-topography. Such texturing enhances water repellency through air entrapment and reduced solid–liquid contact area, consistent with Wenzel/Cassie–Baxter wetting regimes. In addition, AgNPs synthesized using B. populneus extract are coated with phytochemical-derived organic moieties that act as capping agents. This organic layer partially masks surface hydrophilic functional groups and lowers surface free energy, thereby further supporting the transition toward hydrophobic behavior.
Table 2.
Mechanical properties and contact angle measurements of functionalized acrylic samples.
The mechanical properties of the acrylic fabric samples reveal significant changes in tensile strength and elongation as a result of the various chemical treatments applied (Table 2). The AC exhibits a tensile strength of 41.87 N/mm and an elongation of 27.33%, indicating moderate strength and flexibility. Upon amidoximation (TAC), the tensile strength increases substantially to 61.72 N/mm, while the elongation slightly decreases to 25.33%, suggesting that the introduction of amine groups enhances the fabric’s strength, though at a slight cost to its flexibility. The addition of Fe3O4 nanoparticles in the Fe3O4-coated amidoximated acrylic (Fe3O4-TAC) results in a slight decrease in tensile strength to 60.24 N/mm and a more pronounced reduction in elongation to 19.33%, indicating that the fabric becomes stiffer and less flexible due to the added rigidity from the nanoparticles. The most significant increase in tensile strength is observed in the silver nanoparticles loaded on Fe3O4-coated amidoximated acrylic (Ag/Fe3O4-TAC), which reaches 65.32 N/mm, the highest among all samples, while maintaining an elongation of 19.67%. This suggests that the incorporation of silver nanoparticles further reinforces the fabric, enhancing its strength, but the material remains relatively stiff with limited flexibility, similar to the Fe3O4-TAC. The decrease in elongation at break from 27.33% for pristine acrylic fabric (AC) to 19.67% for the final Ag/Fe3O4-TAC sample represents a measurable outcome of the surface modification process and corresponds to an approximately 28% reduction in extensibility. Such behavior is consistent with the literature on functional textile finishing, where nanoparticle coatings and chemical treatments often increase fiber stiffness and restrict polymer-chain mobility, consequently reducing fabric elongation [39]. For example, ZnO nanoparticle-coated cotton fabrics have shown elongation losses ranging from approximately 4% to >12%, depending on coating formulation and the use of binders/auxiliaries [40]. In the present study, the reduction in elongation is accompanied by a substantial increase in tensile strength from 41.87 N/mm to 65.32 N/mm (≈56% improvement), which reflects the formation of a reinforcing hybrid coating layer and enhanced load transfer along the treated fibers. Although reduced extensibility may be less desirable for applications requiring high stretchability and softness, an elongation value of 19.67% remains within an acceptable range for many technical and protective textile applications where antimicrobial/antioxidant performance, dimensional stability, and resistance to mechanical damage are prioritized. Similar reductions in elongation have been reported for other functionalized textiles and were considered acceptable when balanced against the achieved functional gains [41]. Therefore, the resulting mechanical profile of Ag@Fe3O4@TAC can be considered suitable for practical hygienic/technical textile uses, in which moderate elasticity is sufficient.
The antimicrobial results demonstrate the effectiveness of various samples against three bacterial strains: Pseudomonas aeruginosa, Salmonella Typhimurium, and Methicillin-resistant Staphylococcus aureus (MRSA) (Figure 8). The effectiveness of each sample is evaluated by measuring the diameter of the inhibition zone in millimeters (mm), which indicates the extent of bacterial growth suppression. Control samples, AC and TAC, showed no inhibition against any of the tested bacteria, highlighting a lack of antimicrobial activity. Conversely, the Fe3O4-TAC sample displayed limited activity against MRSA, with an inhibition zone of 7 mm, suggesting a modest antimicrobial effect. Notably, the introduction of silver ions significantly enhanced the antimicrobial activity across all strains in the silver-enhanced samples (Ag/Fe3O4-TAC). For instance, with 1 mmol of silver, the inhibition zones were 10 mm against P. aeruginosa, 12 mm against S. Typhimurium, and 11 mm against MRSA. Increasing the silver concentration to 2 mmol resulted in larger inhibition zones of 12 mm for P. aeruginosa, 14 mm for S. Typhimurium, and 12.2 mm for MRSA. Further increases in silver concentration to 3 and 4 mmol consistently improved antimicrobial activity, with the 4 mmol sample achieving inhibition zones of 12.8 mm against P. aeruginosa, 14.4 mm against S. Typhimurium, and 14 mm against MRSA (Figure 9a). These results are consistent with previous research on the antimicrobial properties of Ag/Fe3O4 nanocomposites. Multiple studies have confirmed the efficacy of these nanocomposites against a range of bacterial strains, including both Gram-positive and Gram-negative bacteria [42,43]. For example, Nikmah et al. (2021) demonstrated that SiO2/Ag/Fe3O4 nanoparticles exhibit strong antibacterial effects against E. coli and Bacillus [42], while Ruíz-Baltazar et al. (2023) reported their effectiveness against Staphylococcus aureus (ATCC 6538) and Escherichia coli (ATCC 8739) [43]. Similarly, Ghaseminezhad et al. (2016) found substantial antibacterial properties in iron oxide nanoparticles [44]. The current study establishes a direct relationship between the silver concentration in the Ag/Fe3O4-TAC nanocomposite and its antimicrobial effectiveness against P. aeruginosa, S. Typhimurium, and MRSA. As the silver concentration increased from 1 to 4 mmol, there was a corresponding increase in inhibition zones, indicating enhanced antibacterial efficacy. These observations align with the findings of Chang et al. (2018), who noted that both the size and concentration of silver nanoparticles are critical factors in determining their antibacterial properties [45]. Additionally, a study by Ghaseminezhad et al. (2022) demonstrated that Ag/Fe3O4 nanocomposites possess significant antimicrobial properties, particularly against Gram-negative bacteria like E. coli and P. aeruginosa [46]. At half the minimum inhibitory concentration (MIC), these nanocomposites notably extended the lag phase of bacterial growth, indicating their capacity to delay bacterial proliferation. They also exhibited superior antibacterial effects compared to Ag nanoparticles alone and significantly enhanced antibiofilm activity against P. aeruginosa and MRSA [46]. Similarly, Ghaseminezhad et al. (2016) reported that Ag/Fe3O4 nanocomposites showed potent antibacterial activity against Escherichia coli, as demonstrated through MIC testing [44]. Interestingly, Ag nanoparticles alone killed bacteria more rapidly than the Ag@Fe3O4 nanocomposites, likely due to the gradual release of Ag ions from the nanocomposites embedded within the starch matrix and Fe3O4 agglomerations.
Figure 8.
Antibacterial activity of samples against bacteria including P. aeruginosa, S. Typhimurium, and MRSA. (1) AC, (2) TAC, (3) Fe3O4-TAC, (4) 1 mmol Ag/Fe3O4-TAC, (5) 2 mmol Ag/Fe3O4-TAC, (6) 3 mmol Ag/Fe3O4-TAC, (7) 4 mmol Ag/Fe3O4-TAC.
Figure 9.
Inhibition zone of (a) antibacterial activity of samples against some strains bacteria, (b) antifungal activity of samples against some strains fungi; (1) AC, (2) TAC, (3) Fe3O4-TAC, (4) 1 mmol Ag/Fe3O4-TAC, (5) 2 mmol Ag/Fe3O4-TAC, (6) 3 mmol Ag/Fe3O4-TAC, (7) 4 mmol Ag/Fe3O4-TAC.
The results delineate the antifungal efficacy of various samples against three distinct fungal strains: Aspergillus niger, Trichoderma viride, and Candida albicans. The potency of each sample was assessed by quantifying the diameter of the inhibition zone in millimeters (mm), which serves as an indicator of the degree of fungal growth suppression. samples, comprising AC, TAC, and Fe3O4-TAC, exhibited no antifungal activity against any of the fungal strains subjected to testing, with inhibition zones measuring 0 mm, thereby corroborating the absence of intrinsic antifungal characteristics (Figure 10). Conversely, the silver-enhanced samples (Ag/Fe3O4-TAC) manifested considerable antifungal activity against all tested strains. For instance, at a silver concentration of 1 mmol, the inhibition zones measured 16.2 mm for A. niger, 17 mm for T. viride, and 22.5 mm for C. albicans. An increment in the silver concentration to 2 mmol resulted in an expansion of the inhibition zones to 16.4 mm for A. niger, 16 mm for T. viride, and 24 mm for C. albicans. At 3 mmol, the inhibition zones were recorded at 16 mm for A. niger, 18 mm for T. viride, and 25.8 mm for C. albicans. Ultimately, at the maximum concentration of 4 mmol, the inhibition zones attained 16.4 mm for A. niger, 18.3 mm for T. viride, and 26.9 mm for C. albicans (Figure 9b). The antifungal efficacy of Ag/Fe3O4-TAC against Aspergillus niger, Trichoderma viride, and Candida albicans aligns with antecedent studies that emphasize the effectiveness of silver and iron oxide nanoparticles in the mitigation of fungal pathogens [42,43,47]. In the present investigation, control samples (AC, TAC, and Fe3O4-TAC) demonstrated no antifungal activity, whereas the silver-enhanced samples exhibited substantial inhibition, notably against Candida albicans, with inhibition zones achieving up to 26.9 mm at the highest concentration of silver. These results are corroborated by prior research, which highlights the formidable antifungal properties of silver nanoparticles. For instance, Ruíz-Baltazar et al. (2023) illustrated the remarkable antifungal efficacy of Fe3O4-Ag nanoparticles against various Candida strains, indicating their potential as alternative therapeutic agents for fungal infections resistant to conventional treatments [43]. Similarly, Win et al. (2021) documented that iron oxide nanoparticles demonstrated antifungal effects against several fungal pathogens, with inhibition zones varying from 10 to 25 mm [47]. These findings reinforce the prospective utility of these nanoparticles in effectively inhibiting fungal proliferation. In addition, the anti-microbial performance of Ag-functionalized textiles may originate from contact active mechanisms and/or the release of bioactive silver species; therefore, time-dependent silver release (leaching) studies are strongly recommended to distinguish between a possible burst release and prolonged controlled release/contact effects. Such release profiling (e.g., immersion in water/saline/artificial sweat followed by ICP-OES/ICP-MS quantification of Ag) is also essential to evaluate long-term stability and safety, and to support real-world implementation of the developed fabrics.
Figure 10.
Antifungal activity of samples against fungi including Aspergillus niger, Trichoderma viride, and Candida albicans. (1) AC, (2) TAC, (3) Fe3O4-TAC, (4) 1 mmol Ag/Fe3O4-TAC, (5) 2 mmol Ag/Fe3O4-TAC, (6) 3 mmol Ag/Fe3O4-TAC, (7) 4 mmol Ag/Fe3O4-TAC.
Antioxidant Activity
The antioxidant efficiency of the acrylic fabric specimens, assessed utilizing the DPPH assay, exhibited considerable disparities among the samples throughout 1, 2, and 4 h incubation durations (Figure 11a). The control sample (AC) demonstrated negligible antioxidant activity, functioning as a reference point with an efficacy of 1-fold. The TAC sample revealed a moderate 3-fold augmentation in antioxidant efficacy, suggesting that the treatment absent of silver conferred minimal enhancement in radical scavenging capability. It has been documented that hydroxylamine serves as a reducing agent in Fenton reagent [48]. Considering that the amidoxime moiety is synthesized through the interaction between hydroxylamine and nitrile functionalities, it is anticipated that this moiety will demonstrate reducing characteristics. Therefore, the augmented antioxidant activity observed in the amidoximated textile can plausibly be ascribed to the presence of amidoxime functionalities [5]. The incorporation of Fe3O4 into TAC leads to a remarkable 16-fold increase in antioxidant efficacy, attributed to the iron oxide’s ability to catalyze reactions that neutralize free radicals, such as DPPH [1]. The catalytic characteristics of Fe3O4 allow for effective electron transfer, enhancing the reduction in harmful radicals, which is crucial in textile applications where oxidative stress is a concern [49]. Further augmentation was noted with the incorporation of silver ions; the Ag/Fe3O4-TAC sample containing 1 mmol of silver exhibited a 26-fold increase in antioxidant efficacy, signifying the well-documented radical scavenging capabilities of silver nanoparticles. As the silver concentration escalated to 2 mmol, the antioxidant efficacy surged to 37-fold, implying a synergistic interaction between silver nanoparticles and iron oxide, which intensifies the antioxidant response. However, at silver concentrations of 3 mmol and 4 mmol, the efficacy stabilized at 38-fold, indicating that further increments in silver content did not yield additional improvements in antioxidant activity. This stabilization implies a saturation threshold beyond which the addition of silver does not further enhance the overall antioxidant efficacy, potentially due to the limited availability of active sites for radical interaction or aggregation phenomena occurring at elevated silver concentrations. The impact of AgNPs and phenolics on the antioxidant properties have been reported [5,50,51].
Figure 11.
(a) The DPPH antioxidant efficiency at different times and (b) FRAP reducing power of (1) AC, (2) TAC, (3) Fe3O4-TAC, (4) 1 mmol Ag/Fe3O4-TAC, (5) 2 mmol Ag/Fe3O4-TAC, (6) 3 mmol Ag/Fe3O4-TAC, (7) 4 mmol Ag/Fe3O4-TAC.
To further confirm the results of the DPPH assay, the Ferric Reducing Antioxidant Power (FRAP) assay was performed to measure the reducing power of the studied samples, as shown in Figure 11b. The results demonstrated substantial variations in antioxidant efficiency among the tested samples. The control sample (AC) was set as the baseline with an efficiency of 1-fold. The TAC sample demonstrated a 6-fold increase in antioxidant efficiency, indicating a moderate enhancement due to the treatment. A significant improvement was observed with the Fe3O4-TAC sample, showing a 33-fold increase, which can be attributed to the catalytic properties of iron oxide nanoparticles. Further enhancement was noted with the Ag/Fe3O4-TAC samples, where the addition of silver nanoparticles at concentrations of 1, 2, 3, and 4 mmol resulted in 52-fold, 71-fold, 75-fold, and 78-fold increases in antioxidant efficiency, respectively. This trend suggests a synergistic effect between silver and iron oxide nanoparticles, markedly enhancing the antioxidant capacity. Notably, the antioxidant efficiency plateaued beyond 3 mmol of silver, indicating a saturation effect where additional silver does not significantly contribute to further increases in antioxidant activity
4. Conclusions
This study successfully developed Ag/Fe3O4 nanoparticle-coated acrylic fabrics via green synthesis using Brachychiton populneus extract, achieving significant improvements in antimicrobial, antioxidant, and hydrophobic properties. Amidoximation of acrylic fabrics introduced coordination-active functional groups that enabled efficient immobilization of Fe3O4 nanoparticles, followed by the in situ deposition of AgNPs mediated by the bioactive plant extract, thereby enhancing the surface characteristics and functional performance of the fabrics. The functionalized fabrics exhibited improved surface properties, which supported the observed performance enhancement. Antimicrobial assessments confirmed strong antibacterial and antifungal activity, with inhibition zones of up to 14 mm against bacteria and 26.9 mm against fungi at the highest silver concentration. Antioxidant evaluation demonstrated a pronounced enhancement in reducing power (up to 78-fold), highlighting the synergistic effect of the Ag/Fe3O4 hybrid coating. In addition, the sequential finishing steps were accompanied by a measurable weight gain, confirming the successful deposition of functional layers, with amidoximation increasing the fabric weight by 16.7%, followed by further increases of 10.9% after Fe3O4 coating and 8.5% after AgNP deposition. Such an add-on is consistent with the observed improvement in tensile strength, although it may influence handle/softness in practical textile applications. Moreover, the Fe3O4 coating resulted in a noticeable darkening of the fabric color due to magnetite’s intrinsic black color, which should be considered in end-use applications. Overall, this green synthesis strategy offers a sustainable and scalable pathway for developing multifunctional acrylic fabrics suitable for technical applications such as protective textiles, packaging, filtration, and selected medical textile uses where coloration change is acceptable.
Author Contributions
R.M.E.-S.: Conceptualization, Methodology, Data curation, Investigation, Methodology Writing—review and editing. R.A.Z.: Data curation, Investigation, Writing—review and editing, Funding acquisition. S.M.A.-M.: Data curation, Investigation, Writing—review and editing. N.S.E.A.: Data curation, Investigation, Writing—review and editing. Y.Q.A.: Data curation, Investigation, Methodology Writing—original draft. All authors have read and agreed to the published version of the manuscript.
Funding
This Project was funded by the Deanship of Scientific Research (DSR) at King Abdulaziz University, Jeddah, Saudi Arabia under grant no. (IPP: 380-247-2025). The authors, therefore, acknowledge with thanks DSR technical and financial support.
Data Availability Statement
The original contributions presented in this study are included in the article. Further inquiries can be directed to the corresponding author(s).
Conflicts of Interest
The authors declare no conflict of interest.
References
- Rosa, R.P.; Rosace, G.; Trovato, V. Recent Advancements in Acrylic Fabric Applications: A Comprehensive Review and Future Trends. Polymers 2024, 16, 2111. [Google Scholar] [CrossRef]
- Gupta, B.S.; Afshari, M. Polyacrylonitrile fibers. In Handbook of Properties of Textile and Technical Fibres; Woodhead Publishing: Cambridge, UK, 2018; pp. 545–593. [Google Scholar]
- Torres JÁ, J.; Cabrera, M.L.C.; Romero, D.M.; Torres Avila, I.P.; Goiz, O.; Cruz-Leal, M. Antimicrobial Textile Finishing Based on Silver Nanostructures. Textiles 2025, 5, 61. [Google Scholar] [CrossRef]
- Jalali, E.; Erasmus, E.; Schutte-Smith, M.; Visser, H.G. Fixation of nanoparticles on fabric: Applications in general health management. Mater. Today Commun. 2024, 41, 110577. [Google Scholar] [CrossRef]
- Allehyani, E.S.; Almulaiky, Y.Q.; Al-Harbi, S.A.; El-Shishtawy, R.M. Polydopamine-AgNPs coated acrylic fabric for antimicrobial and antioxidant textiles. J. Coat. Technol. Res. 2023, 20, 1133–1143. [Google Scholar] [CrossRef]
- Yang, H.; Zhu, S.; Pan, N. Studying the mechanisms of titanium dioxide as ultraviolet-blocking additive for films and fabrics by an improved scheme. J. Appl. Polym. Sci. 2004, 92, 3201–3210. [Google Scholar] [CrossRef]
- Gîfu, I.C.; Maxim, M.E.; Cinteza, L.O.; Popa, M.; Aricov, L.; Leontieș, A.R.; Anastasescu, M.; Anghel, D.-F.; Ianchis, R.; Ninciuleanu, C.M.; et al. Antimicrobial activities of hydrophobically modified poly (acrylate) films and their complexes with different chain length cationic surfactants. Coatings 2019, 9, 244. [Google Scholar] [CrossRef]
- El Gabry, L.K.; Abou El-Kheir, A.A.; El-Sayad, H.S.; El-Kashouty, M.A. Ecofriendly modification of acrylic fabrics for enhanced transfer printability. Fibers Polym. 2021, 22, 421–429. [Google Scholar] [CrossRef]
- Jumrus, N.; Jompaeng, J.; Panthawan, A.; Kumpika, T.; Kantarak, E.; Singjai, P.; Thongsuwan, W. Influence of annealing and etching on physical and wetting properties of acrylic surface. Suan Sunandha Sci. Technol. J. 2023, 10, 222–226. [Google Scholar] [CrossRef]
- Orasugh, J.T.; Temane, L.T.; Kesavan Pillai, S.; Ray, S.S. Advancements in antimicrobial textiles: Fabrication, mechanisms of action, and applications. ACS Omega 2025, 10, 12772–12816. [Google Scholar] [CrossRef]
- Gupta, V.; Karthick, B.; Singh, V.B. Application of nanotechnology in the development of smart textiles for allied industries. In Nanoscale Textile Coatings for Enhanced Performance; Springer Nature: Singapore, 2024; pp. 267–290. [Google Scholar]
- Jain, A.; Kongkham, B.; Puttaswamy, H.; Butola, B.S.; Malik, H.K.; Malik, A. Development of wash-durable antimicrobial cotton fabrics by in situ green synthesis of silver nanoparticles and investigation of their antimicrobial efficacy against drug-resistant bacteria. Antibiotics 2022, 11, 864. [Google Scholar] [CrossRef]
- Tabrizi, E.; Li, B. Silver Integrated Hybrids and Nanocomposites for Next-Generation Biomedicine: Beyond Antimicrobial Coatings toward Smart Sense–Response–Heal Platforms. Materials Today Bio 2025, 2025, 102609. [Google Scholar] [CrossRef] [PubMed]
- Aldosari, B.N.; Abd El-Aal, M.; Abo Zeid, E.F.; Faris, T.M.; Aboelela, A.; Abdellatif, A.A.; Tawfeek, H.M. Synthesis and characterization of magnetic Ag–Fe3O4@ polymer hybrid nanocomposite systems with promising antibacterial application. Drug Dev. Ind. Pharm. 2023, 49, 723–733. [Google Scholar] [CrossRef] [PubMed]
- Kiani, G.R.; Sheikhloie, H.; Arsalani, N. Heavy metal ion removal from aqueous solutions by functionalized polyacrylonitrile. Desalination 2011, 269, 266–270. [Google Scholar] [CrossRef]
- Liu, X.; Chen, H.; Wang, C.; Qu, R.; Ji, C.; Sun, C.; Zhang, Y. Synthesis of porous acrylonitrile/methyl acrylate copolymer beads by suspended emulsion polymerization and their adsorption properties after amidoximation. J. Hazard. Mater. 2010, 175, 1014–1021. [Google Scholar] [CrossRef]
- Barybin, M.V.; Diaconescu, P.L.; Cummins, C.C. Coordination chemistry of a chelating amidoximato ligand. Inorg. Chem. 2001, 40, 2892–2897. [Google Scholar] [CrossRef]
- Wu, T.; Liu, C.; Kong, B.; Sun, J.; Gong, Y.; Liu, K.; Xie, J.; Pei, A.; Cui, Y. Amidoxime-functionalized macroporous carbon self-refreshed electrode materials for rapid and high-capacity removal of heavy metal from water. ACS Cent. Sci. 2019, 5, 719–726. [Google Scholar] [CrossRef]
- Mohd Zahri, N.A.; Md Jamil, S.N.A.; Chuah Abdullah, L.; Choong Shean Yaw, T.; Nourouzi Mobarekeh, M.; Jia Huey, S.; Mohd Rapeia, N.S. Improved method for preparation of amidoxime modified poly (acrylonitrile-co-acrylic acid): Characterizations and adsorption case study. Polymers 2015, 7, 1205–1220. [Google Scholar] [CrossRef]
- Almulaiky, Y.Q.; Al-Harbi, S.A. Innovative immobilization of β-glucosidase on amidoximated acrylic fabric integrated with magnetite Fe3O4 nanoparticles. Int. J. Biol. Macromol. 2025, 2025, 141172. [Google Scholar] [CrossRef]
- Choi, S.H.; Nho, Y.C. Adsorption of UO2+ 2 by polyethylene adsorbents with amidoxime, carboxyl, and amidoxime/carboxyl group. Radiat. Phys. Chem. 2000, 57, 187–193. [Google Scholar] [CrossRef]
- Shaaban, A.F.; Fadel, D.A.; Mahmoud, A.A.; Elkomy, M.A.; Elbahy, S.M. Synthesis of a new chelating resin bearing amidoxime group for adsorption of Cu (II), Ni (II) and Pb (II) by batch and fixed-bed column methods. J. Environ. Chem. Eng. 2014, 2, 632–641. [Google Scholar] [CrossRef]
- Ge, F.; Li, M.M.; Ye, H.; Zhao, B.X. Effective removal of heavy metal ions Cd2+, Zn2+, Pb2+, Cu2+ from aqueous solution by polymer-modified magnetic nanoparticles. J. Hazard. Mater. 2012, 211, 366–372. [Google Scholar] [CrossRef]
- Becker, O.; Varley, R.; Simon, G. Morphology, thermal relaxations and mechanical properties of layered silicate nanocomposites based upon high-functionality epoxy resins. Polymer 2002, 43, 4365–4373. [Google Scholar] [CrossRef]
- Ngo, T.D.; Le, T.M.H.; Nguyen, T.H.; Nguyen, T.V.; Nguyen, T.A.; Le, T.L.; Nguyen, T.T.; Van Tran, T.T.; Thao Le, T.B.; Doan, N.H. Antibacterial Nanocomposites Based on Fe3O4–Ag Hybrid Nanoparticles and Natural Rubber-Polyethylene Blends. Int. J. Polym. Sci. 2016, 2016, 7478161. [Google Scholar] [CrossRef]
- Jafari, B.; Lacerda, C.M.; Botte, G.G. Facile electrochemical preparation of hydrophobic antibacterial fabrics using reduced graphene oxide/silver nanoparticles. ChemElectroChem 2023, 10, e202201111. [Google Scholar] [CrossRef]
- Hamouda, T.; Aly, N.M.; Elshakankery, M.H. An experimental study on the interaction between braiding structural parameters and their effects on ropes mechanical properties. J. Ind. Text. 2022, 51, 1467–1493. [Google Scholar] [CrossRef]
- Foti, M.C.; Daquino, C.; Geraci, C. Electron-transfer reaction of cinnamic acids and their methyl esters with the DPPH•radical in alcoholic solutions. J. Org. Chem. 2004, 69, 2309–2314. [Google Scholar] [CrossRef]
- Benzie, I.F.; Strain, J.J. The ferric reducing ability of plasma (FRAP) as a measure of “antioxidant power”: The FRAP assay. Anal. Biochem. 1996, 239, 70–76. [Google Scholar] [CrossRef]
- Kumar, D.A.; Palanichamy, V.; Roopan, S.M. Green synthesis of silver nanoparticles using Alternanthera dentata leaf extract at room temperature and their antimicrobial activity. Spectrochim. Acta Part A Mol. Biomol. Spectrosc. 2014, 127, 168–171. [Google Scholar] [CrossRef]
- Kumari, M.; Pittman, C.U., Jr.; Mohan, D. Heavy metals [chromium (VI) and lead (II)] removal from water using mesoporous magnetite (Fe3O4) nanospheres. J. Colloid Interface Sci. 2015, 442, 120–132. [Google Scholar] [CrossRef]
- Mohamed, S.A.; Al-Harbi, M.H.; Almulaiky, Y.Q.; Ibrahim, I.H.; El-Shishtawy, R.M. Immobilization of horseradish peroxidase on Fe3O4 magnetic nanoparticles. Electron. J. Biotechnol. 2017, 27, 84–90. [Google Scholar] [CrossRef]
- El-Shishtawy, R.M.; Asiri, A.M.; Abdelwahed, N.A.; Al-Otaibi, M.M. In situ production of silver nanoparticle on cotton fabric and its antimicrobial evaluation. Cellulose 2011, 18, 75–82. [Google Scholar] [CrossRef]
- Corbellini, L.; Plathier, J.; Lacroix, C.; Harnagea, C.; Ménard, D.; Pignolet, A. Hysteresis loops revisited: An efficient method to analyze ferroic materials. J. Appl. Phys. 2016, 120, 124101. [Google Scholar] [CrossRef]
- Ikemiya, K.; Konishi, K.; Fujii, E.; Kogure, T.; Kuwata-Gonokami, M.; Hasegawa, T. Self-assembly and plasmon-enhanced ultrafast magnetization of Ag–Co hybrid nanoparticles. Opt. Mater. Express 2014, 4, 1564–1573. [Google Scholar] [CrossRef]
- Tsau, J.S.; Barati, R.G.; Zaghloul, J.; Alhajeri, M.M.; Bradford, K.; Nicoud, B. Experimental investigation of high pressure, high temperature (HPHT) adsorption of methane and natural gas on shale gas samples. In Abu Dhabi International Petroleum Exhibition and Conference; SPE: Bellingham, WA, USA, 2022; p. D021S034R001. [Google Scholar]
- Marco-Lozar, J.P.; Kunowsky, M.; Suárez-García, F.; Carruthers, J.D.; Linares-Solano, A. Activated carbon monoliths for gas storage at room temperature. Energy Environ. Sci. 2012, 5, 9833–9842. [Google Scholar] [CrossRef]
- Söllner, J.; Neimark, A.V.; Thommes, M. Development and application of an advanced percolation model for pore network characterization by physical adsorption. Langmuir 2024, 40, 23146–23168. [Google Scholar] [CrossRef]
- Veselova, V.O.; Plyuta, V.A.; Kostrov, A.N.; Vtyurina, D.N.; Abramov, V.O.; Abramova, A.V.; Voitov, Y.I.; Padiy, D.A.; Hoai Thu, V.T.; Hue, L.T.; et al. Long-term antimicrobial performance of textiles coated with ZnO and TiO2 nanoparticles in a tropical climate. J. Funct. Biomater. 2022, 13, 233. [Google Scholar] [CrossRef]
- Tania, I.S.; Ali, M. Coating of ZnO nanoparticle on cotton fabric to create a functional textile with enhanced mechanical properties. Polymers 2021, 13, 2701. [Google Scholar] [CrossRef]
- Allehyani, E.S. Surface functionalization of polyester textiles for antibacterial and antioxidant properties. Polymers 2022, 14, 5512. [Google Scholar] [CrossRef]
- Nikmah, A.; Taufiq, A.; Hidayat, A.; Sunaryono; Susanto, H. Excellent antimicrobial activity of Fe3O4/SiO2/Ag nanocomposites. Nano 2021, 16, 2150049. [Google Scholar] [CrossRef]
- Ruíz-Baltazar, Á.D.J.; Böhnel, H.N.; Larrañaga Ordaz, D.; Cervantes-Chávez, J.A.; Méndez-Lozano, N.; Reyes-López, S.Y. Green Ultrasound-Assisted Synthesis of Surface-Decorated Nanoparticles of Fe3O4 with Au and Ag: Study of the Antifungal and Antibacterial Activity. J. Funct. Biomater. 2023, 14, 304. [Google Scholar] [CrossRef]
- Ghaseminezhad, S.M.; Shojaosadati, S.A. Evaluation of the antibacterial activity of Ag/Fe3O4 nanocomposites synthesized using starch. Carbohydr. Polym. 2016, 144, 454–463. [Google Scholar] [CrossRef] [PubMed]
- Chang, M.; Lin, W.S.; Xiao, W.; Chen, Y.N. Antibacterial effects of magnetically-controlled Ag/Fe3O4 nanoparticles. Materials 2018, 11, 659. [Google Scholar] [CrossRef]
- Ghaseminezhad, S.M.; Hamedi, S.; Shojaosadati, S.A. Evaluation of antimicrobial property of Ag/Fe3O4 nanocomposites synthesized with starch. Nashrieh Shimi Va Mohandesi Shimi Iran 2022, 41, 1–12. [Google Scholar]
- Win, T.T.; Khan, S.; Bo, B.; Zada, S.; Fu, P. Green synthesis and characterization of Fe3O4 nanoparticles using Chlorella-K01 extract for potential enhancement of plant growth stimulating and antifungal activity. Sci. Rep. 2021, 11, 21996. [Google Scholar] [CrossRef]
- Chen, L.; Ma, J.; Li, X.; Zhang, J.; Fang, J.; Guan, Y.; Xie, P. Strong enhancement on Fenton oxidation by addition of hydroxylamine to accelerate the ferric and ferrous iron cycles. Environ. Sci. Technol. 2011, 45, 3925–3930. [Google Scholar] [CrossRef]
- Li, A.; Zhu, A. Preparation of Fe3O4/PANI nanocomposite and its metal anticorrosive activity. Prog. Org. Coat. 2021, 161, 106477. [Google Scholar] [CrossRef]
- Zahrani, N.A.A.; El-Shishtawy, R.M.; Asiri, A.M. Recent developments of gallic acid derivatives and their hybrids in medicinal chemistry: A review. Eur. J. Med. Chem. 2020, 204, 112609. [Google Scholar] [CrossRef] [PubMed]
- Al Zahrani, N.A.; El-Shishtawy, R.M.; Elaasser, M.M.; Asiri, A.M. Synthesis of novel chalcone-based phenothiazine derivatives as antioxidant and anticancer agents. Molecules 2020, 25, 4566. [Google Scholar] [CrossRef] [PubMed]
Disclaimer/Publisher’s Note: The statements, opinions and data contained in all publications are solely those of the individual author(s) and contributor(s) and not of MDPI and/or the editor(s). MDPI and/or the editor(s) disclaim responsibility for any injury to people or property resulting from any ideas, methods, instructions or products referred to in the content. |
© 2026 by the authors. Licensee MDPI, Basel, Switzerland. This article is an open access article distributed under the terms and conditions of the Creative Commons Attribution (CC BY) license.